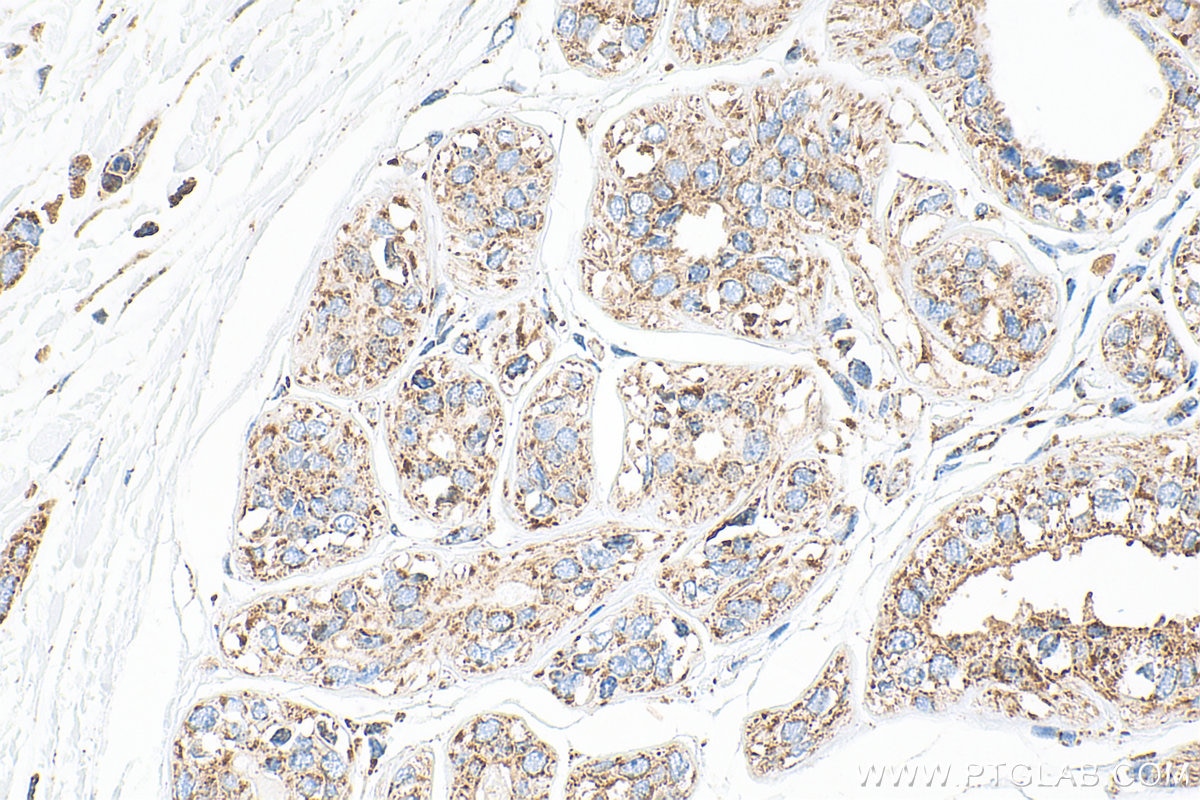
Immunohistochemistry (IHC) staining of human breast cancer tissue using SYTL2 Polyclonal antibody (12359-1-AP)

Tested Applications
| Positive WB detected in | A549 cells, Jurkat cells, MCF-7 cells |
| Positive IHC detected in | human breast cancer tissue Note: suggested antigen retrieval with TE buffer pH 9.0; (*) Alternatively, antigen retrieval may be performed with citrate buffer pH 6.0 |
Recommended dilution
| Application | Dilution |
|---|---|
| Western Blot (WB) | WB : 1:500-1:3000 |
| Immunohistochemistry (IHC) | IHC : 1:200-1:800 |
| It is recommended that this reagent should be titrated in each testing system to obtain optimal results. | |
| Sample-dependent, Check data in validation data gallery. | |
Published Applications
| KD/KO | See 1 publications below |
| WB | See 1 publications below |
| IHC | See 1 publications below |
Product Information
12359-1-AP targets SYTL2 in WB, IHC, ELISA applications and shows reactivity with human samples.
| Tested Reactivity | human |
| Cited Reactivity | human |
| Host / Isotype | Rabbit / IgG |
| Class | Polyclonal |
| Type | Antibody |
| Immunogen |
CatNo: Ag3023 Product name: Recombinant human SYTL2 protein Source: e coli.-derived, PGEX-4T Tag: GST Domain: 7-382 aa of BC015540 Sequence: MSKSVPAFLQDESDDRETDTASESSYQLSRHKKSPSSLTNLSSSSGMTSLSSVSGSVMSVYSGDFGNLEVKGNIQFAIEYVESLKELHVFVAQCKDLAAADVKKQRSDPYVKAYLLPDKGKMGKKKTLVVKKTLNPVYNEILRYKIEKQILKTQKLNLSIWHRDTFKRNSFLGEVELDLETWDWDNKQNKQLRWYPLKRKTAPVALEAENRGEMKLALQYVPEPVPGKKLPTTGEVHIWVKECLDLPLLRGSHLNSFVKCTILPDTSRKSRQKTRAVGKTTNPIFNHTMVYDGFRPEDLMEACVELTVWDHYKLTNQFLGGLRIGFGTGKSYGTEVDWMDSTSEEVALWEKMVNSPNTWIEATLPLRMLLIAKISK Predict reactive species |
| Full Name | synaptotagmin-like 2 |
| Calculated Molecular Weight | 934 aa, 105 kDa |
| Observed Molecular Weight | 39 kDa, 100-105 kDa |
| GenBank Accession Number | BC015540 |
| Gene Symbol | SYTL2 |
| Gene ID (NCBI) | 54843 |
| RRID | AB_11182492 |
| Conjugate | Unconjugated |
| Form | Liquid |
| Purification Method | Antigen affinity purification |
| UNIPROT ID | Q9HCH5 |
| Storage Buffer | PBS with 0.02% sodium azide and 50% glycerol, pH 7.3. |
| Storage Conditions | Store at -20°C. Stable for one year after shipment. Aliquoting is unnecessary for -20oC storage. 20ul sizes contain 0.1% BSA. |
Background Information
Synaptotagmin-like 2 (SYTL2) is a synaptotagmin-like protein (SLP) that belongs to a C2 domain-containing protein family. SYTL2 contains an N-terminal Slp homology domain (SHD), Rab-binding region, and C-terminal tandem C2 domains, C2A and C2B (PMID: 11327731). It interacts with RAB27A and plays a role in promoting docking of RAB27-bound organelles to the plasma membrane (PMID: 17052176). Alternative splicing of SYTL2 gene results in multiple transcript variants encoding distinct isoforms with calculated molecular weights ranging from 39 kDa to 142 kDa.
Protocols
| Product Specific Protocols | |
|---|---|
| IHC protocol for SYTL2 antibody 12359-1-AP | Download protocol |
| WB protocol for SYTL2 antibody 12359-1-AP | Download protocol |
| Standard Protocols | |
|---|---|
| Click here to view our Standard Protocols |
Publications
| Species | Application | Title |
|---|---|---|
J Extracell Vesicles Suppression of PD‐L1 release from small extracellular vesicles promotes systemic anti‐tumor immunity by targeting ORAI1 calcium channels
| ||
Nat Commun ASPSCR1::TFE3 orchestrates the angiogenic program of alveolar soft part sarcoma |